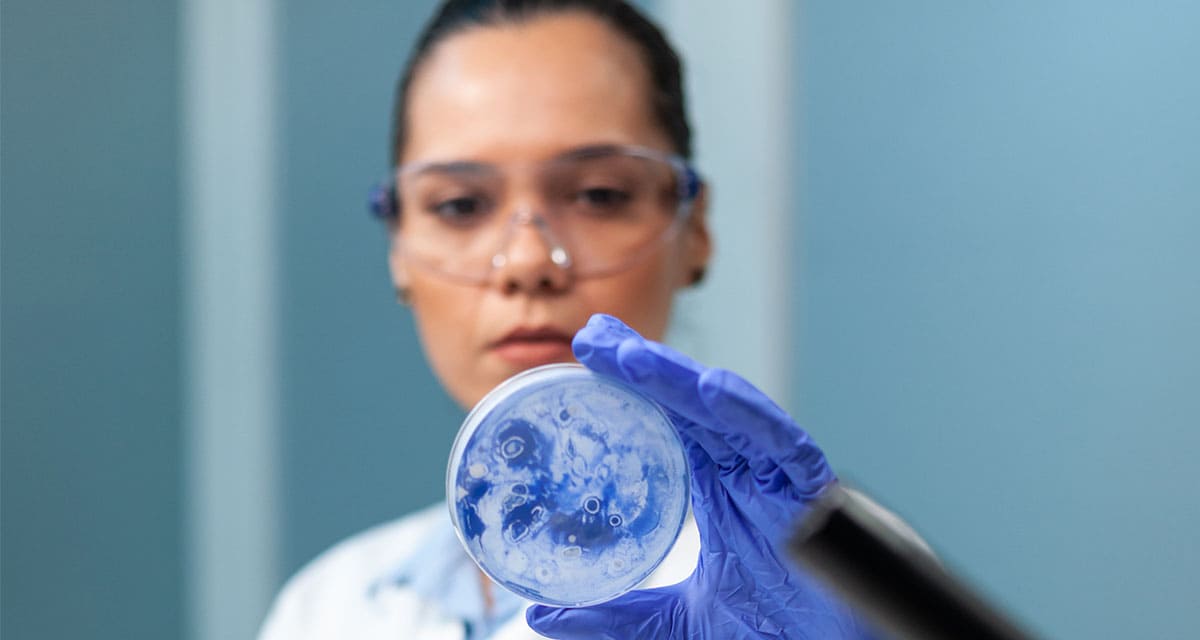

Normatividad y regulaciones
CE presenta regulación de Nuevas Técnicas Genómicas
Las Nuevas Técnicas Genómicas abren la puerta a la alimentación del futuro, pero advierten la seguridad alimentaria
Última actualización:

Newsletter
Lo último
Normatividad y regulaciones
CE presenta regulación de Nuevas Técnicas Genómicas
Las Nuevas Técnicas Genómicas abren la puerta a la alimentación del futuro, pero advierten la seguridad alimentaria
Última actualización:
Newsletter
Lo último
